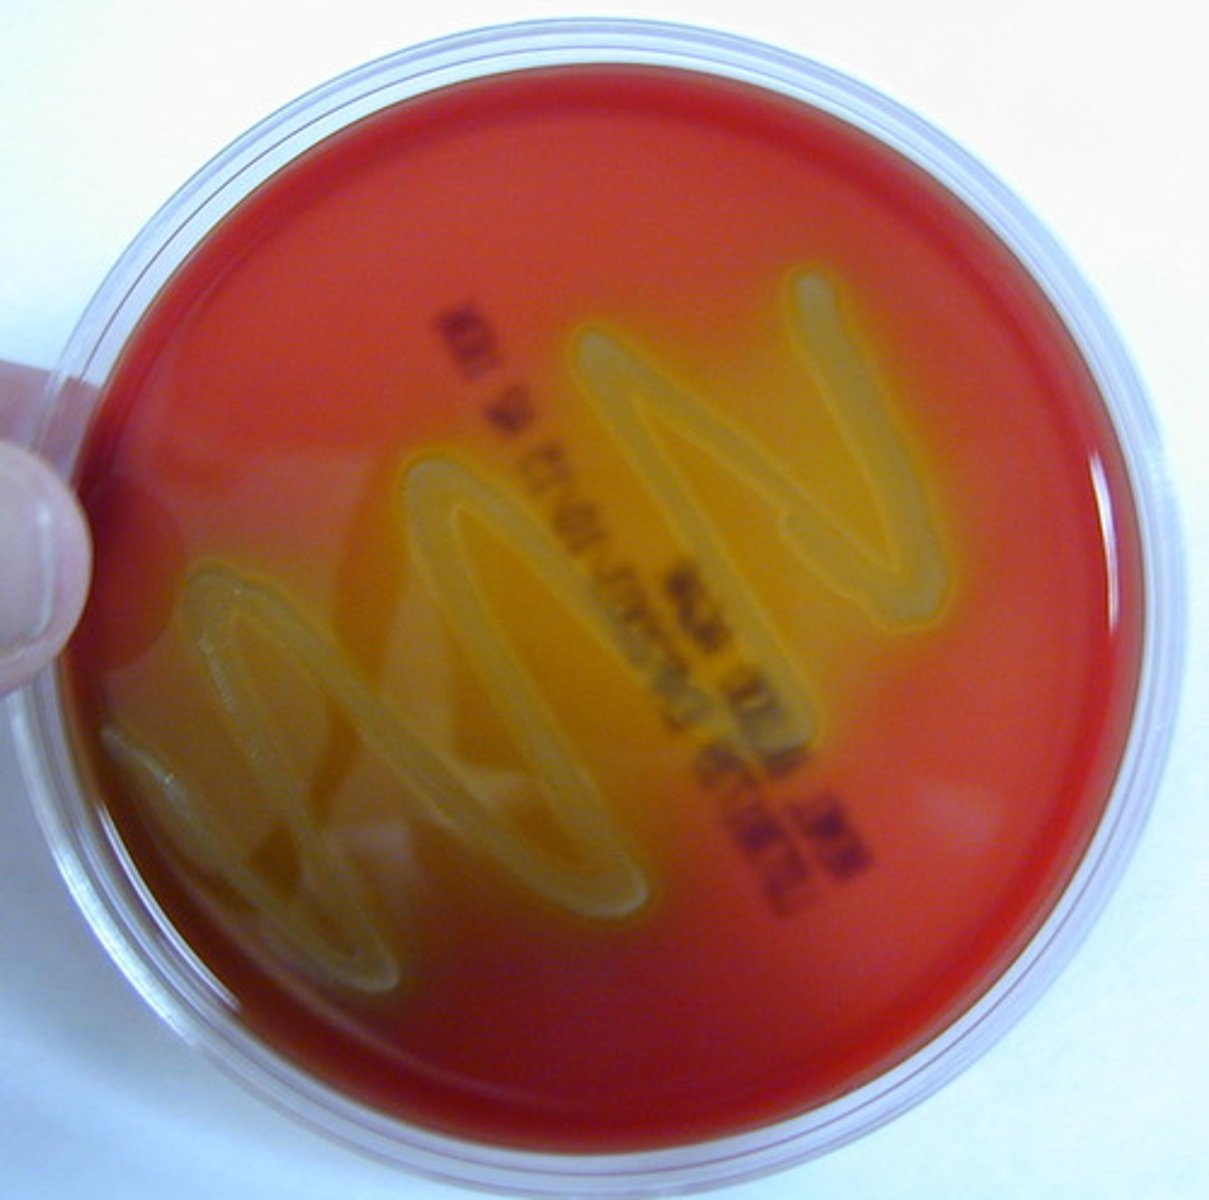
knowt flashcard image
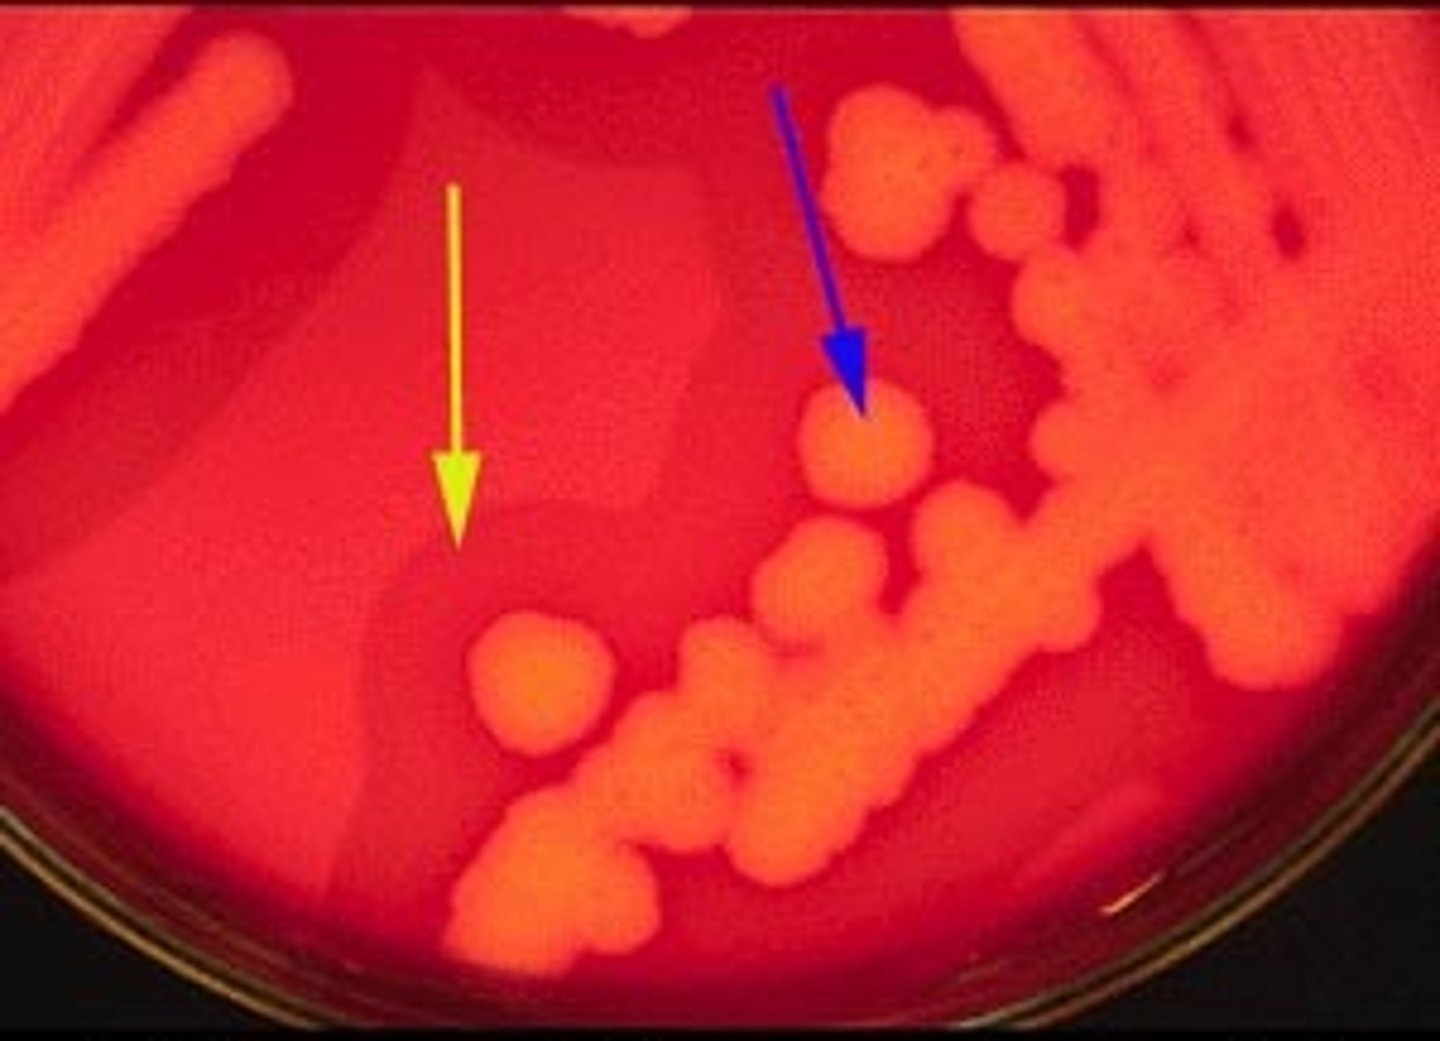
knowt flashcard image
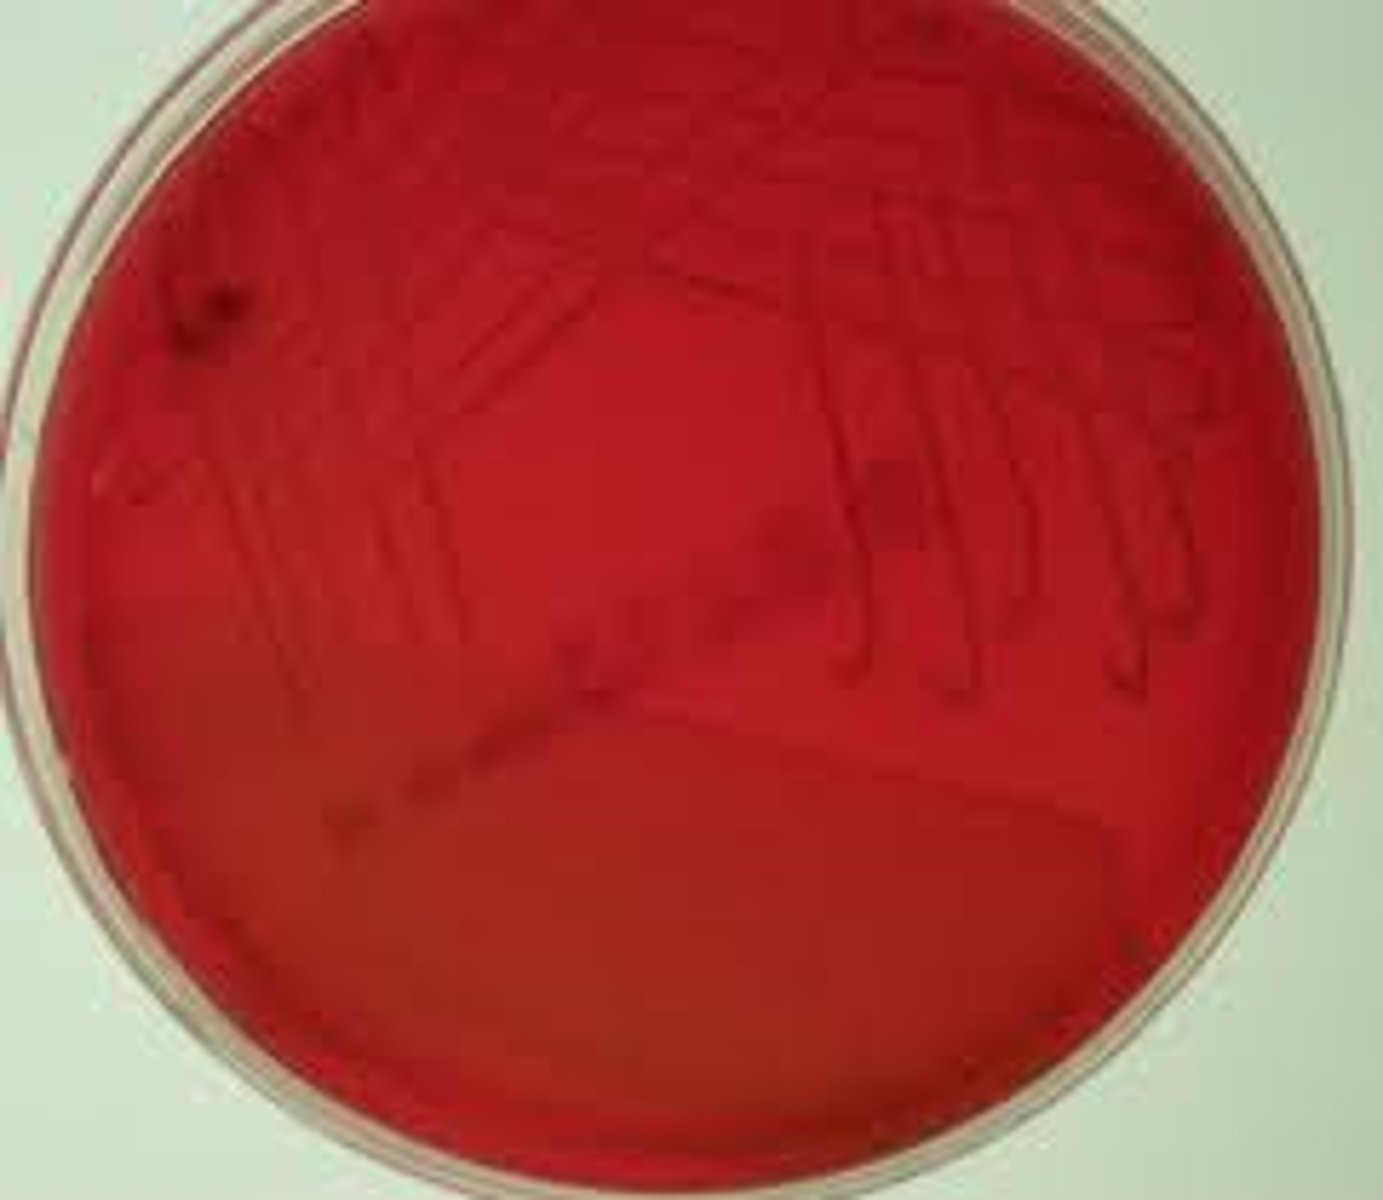
knowt flashcard image

1/18
Looks like no tags are added yet.
Name | Mastery | Learn | Test | Matching | Spaced |
|---|
No study sessions yet.
alpha hemolysis
beta hemolysis
gamma hemolysis
catalase test
Differentiates Staphylococcus (catalase positive) from Streptococcus
coagulase test
differentiates staphylococcus aureus (coagulase positive) from other staphylococci
Schistosoma japonicum

Amoeba proteus

aspergillis conidiospores

helminth eggs

budding yeast

giardia

Plasmodium falciparum

Rhizopus sporangia

body louse

Trichinella cyst

trypanosoma gambia

Taenia proglottids

tinea pedis microscope

pneumocystis pneumonia
